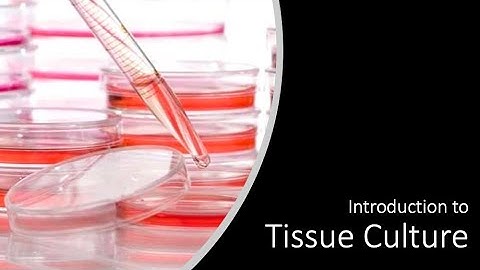

⬇ DOWNLOAD NOW
Kalau muncul iklan pop-up, tutup lalu klik tombol kembali
Download lagu 1) Cell Culture Tutorial - An Introduction secara gratis hanya untuk keperluan promosi. Dukung artis favorit kamu dengan membeli musik original di iTunes atau platform resmi lainnya.
 Cell Culture Video: Step-by-Step Guide to Passaging Cells
Cell Culture Video: Step-by-Step Guide to Passaging Cells
 1. Cell culture laboratory and equipment overview
1. Cell culture laboratory and equipment overview
Introduction to Cell Culture
Introduction to Cell Culture
 Bioprocessing Cell Culture Overview – Two Minute Tuesday Video
Bioprocessing Cell Culture Overview – Two Minute Tuesday Video
 MSU Cell Biology (BIO320) - Lab 1: Cell Culturing (Video 5)
MSU Cell Biology (BIO320) - Lab 1: Cell Culturing (Video 5)
 Thawing Cells: Cell Culture Basics
Thawing Cells: Cell Culture Basics
 Mammalian cell culture 1 - introduction to cell culture
Mammalian cell culture 1 - introduction to cell culture
 Introduction to cell culture, splitting cells using trypsin and counting them using a hemocytometer
Introduction to cell culture, splitting cells using trypsin and counting them using a hemocytometer